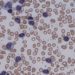
The CLL14 trial: longer progression-free survival for CLL patients with coexisting conditions treated with venetoclax

Once-weekly tirzepatide significantly improves weight and glycemic control in patients with with obesity and type 2 diabetes
1. Body weight reduction at week 72 was significantly greater with tirzepatide versus placebo.
2. Hemoglobin A1c was significantly reduced with tirzepatide versus placebo.
Evidence Rating Level: 1 (Excellent)
Study Rundown: Obesity is a chronic disease that is expected to affect nearly 2 billion people by 2035. Although weight reduction is a key component of type 2 diabetes management, few drugs exist with a dual effect on both body weight and glycemic control. Tirzepatide is a subcutaneous glucagon-like peptide-1 (GLP-1) and glucose-dependent insulinotropic peptide (GIP) agonist that may have this effect, although the current evidence is limited. This randomized controlled trial aimed to assess the safety and efficacy of tirzepatide versus placebo in bodyweight reduction among adults with obesity and type 2 diabetes. The primary outcome of this study was the percent change in body weight from baseline, while a key secondary outcome was a reduction in body weight by at least 5%. According to study results, tirzepatide significantly reduced body weight in patients compared to placebo with a favourable safety profile. This study was strengthened by a longitudinal follow-up period, thus increasing the validity of the results.
Click to read the study in The Lancet
Relevant Reading: Tirzepatide Once Weekly for the Treatment of Obesity
In-depth [randomized-controlled trial]: Between Mar 29, 2021, and Apr 10, 2023, 1514 patients were screened for eligibility across 7 countries. Included were patients aged ≥18 years with a BMI ≥ 27 kg/m² and HbA1c of 7–10%. Altogether, 938 patients (312 in tirzepatide 10 mg, 311 in tirzepatide 15 mg, and 315 in placebo) were included in the final analysis. The primary outcome of bodyweight reduction at week 72 was greatest in the tirzepatide 15 mg group (-14.7%, standard error [SE] 0.5) followed by tirzepatide 10 mg (-12.8%, SE 0.6) and placebo (-3.2%, SE 0.5; p<0.001 for all). This was also the case for the secondary outcome concerning a ≥ 5% reduction in body weight (79-83% for tirzepatide vs. 32% for placebo). Compared to baseline values, patients receiving tirzepatide 10 mg (-2.1%, SE 0.06) and 15 mg (-2.1%, SE 0.07) had significant reductions in their hemoglobin A1c compared to placebo (-0.5%, SE 0.07; p<0.0001 for all) after 72-weeks. The majority of treatment-related side effects were mild-to-moderate in nature and included nausea, diarrhea, and vomiting. Overall, findings from this study suggest that once-weekly tirzepatide, at 10 mg and 15 mg doses, substantially reduces body weight and improves glycemic control in adults with obesity and type 2 diabetes.
Image: PD
©2023 2 Minute Medicine, Inc. All rights reserved. No works may be reproduced without expressed written consent from 2 Minute Medicine, Inc. Inquire about licensing here. No article should be construed as medical advice and is not intended as such by the authors or by 2 Minute Medicine, Inc.